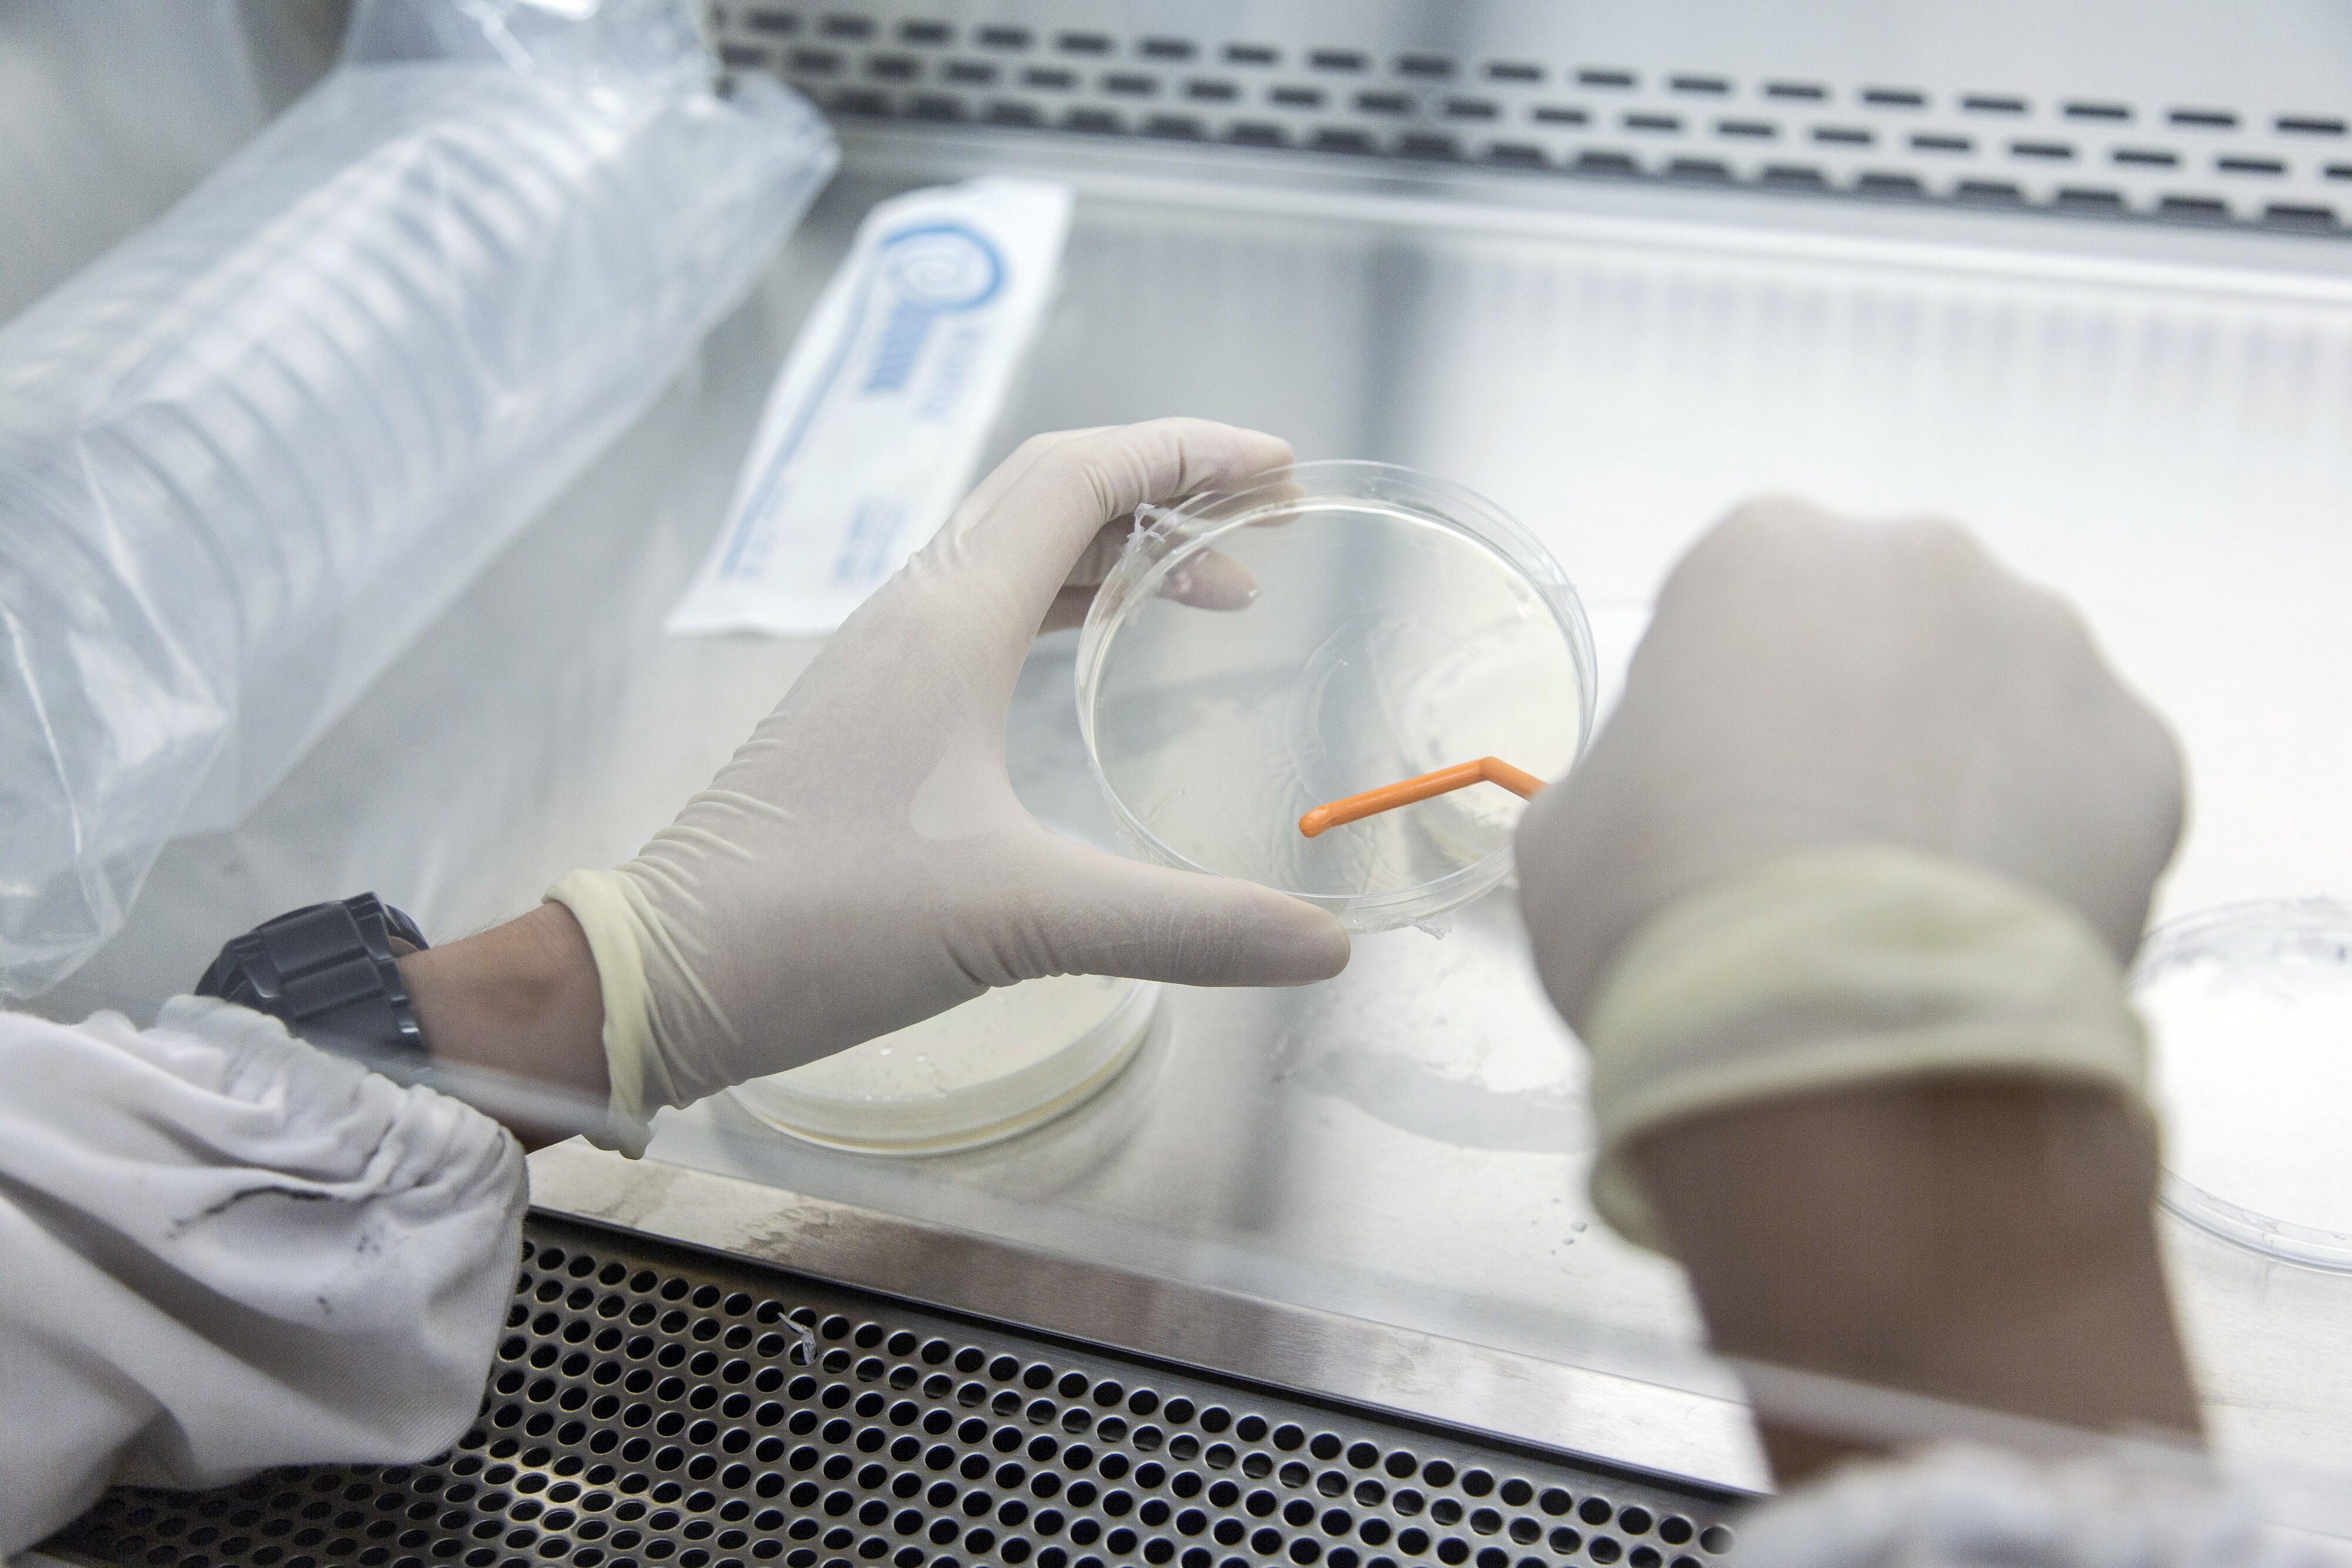

Drugmaker Granules India Ltd. on Thursday announced divestment of its entire stake in its joint venture firm Granules OmniChem to its JV partner for an undisclosed sum.
Granules OmniChem is an equal joint venture of Granules lndia and SA Ajinomoto Omnichem NV. The conclusion of this transaction is subject to fulfilment of certain closing conditions as well as customary government approvals.
"The proposed divestment of our 50 percent stake in the joint venture aligns with our focus on strengthening our core area of business. With this transaction, SA Ajinomoto Omnichem NV will take over full control of the contract research and manufacturing services business," Granules India said in a regulatory filing.
"Through this deal, we would like to extend our support to our joint venture partner for their business plan to integrate their small and large molecule businesses which in turn strengthens their business operation and client relations," said Krishna Prasad Chigurupati, chairman and managing director at Granules India, said in the exchange filing.
Granules OmniChem's manufacturing facility is located in Visakhapatnam.
On Thursday, Granules India shares fell 2.32 percent to Rs 90.55 apiece on the BSE while the benchmark Sensex shed 1.02 percent to end the day at 37,068.93 points.
Essential Business Intelligence, Continuous LIVE TV, Sharp Market Insights, Practical Personal Finance Advice and Latest Stories — On NDTV Profit.























